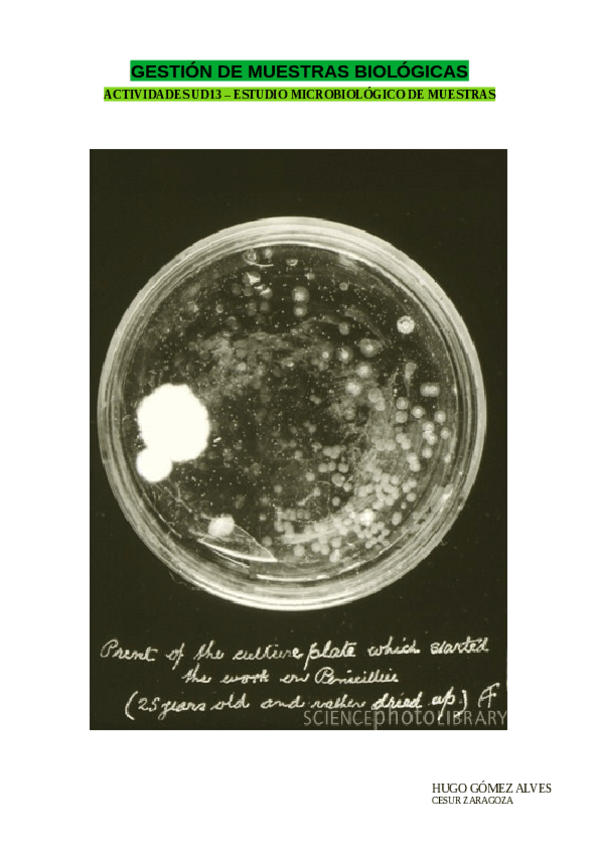

Gestión de muestras biológicas
apuntes
-
3 EVALUACIÓN
He publicado nuevos apuntes de Gestión de muestras biológicas: 3 EVALUACIÓN
apuntes
-
2 EVALUACIÓN
He publicado nuevos apuntes de Gestión de muestras biológicas: 2 EVALUACIÓN
apuntes
-
1 EVALUACIÓN
He publicado nuevos apuntes de Gestión de muestras biológicas: 1 EVALUACIÓN
examenes
Hola, alguien sabe donde puedo encontrar examenes de años anteriores de grado superior de laboratorio clinico y biomedico?
He publicado nuevos apuntes de Gestión de muestras biológicas: TEMA-4-CALIDAD-Y-SEGURIDAD.pdf
He publicado nuevos apuntes de Gestión de muestras biológicas: Tema-11-Gestion-de-Muestras.pdf
He publicado nuevos apuntes de Gestión de muestras biológicas: Tema-10-Gestion-de-Muestras.pdf
He publicado nuevos apuntes de Gestión de muestras biológicas: Tema-9-Gestion-de-Muestras.pdf
He publicado nuevos apuntes de Gestión de muestras biológicas: Tema-8-Gestion-de-Muestras.pdf
He publicado nuevos apuntes de Gestión de muestras biológicas: Tema-7-Gestion-de-Muestras.pdf
He publicado nuevos apuntes de Gestión de muestras biológicas: Tema-6-Gestion-de-Muestras.pdf
He publicado nuevos apuntes de Gestión de muestras biológicas: Tema-5-Gestion-de-Muestras.pdf
He publicado nuevos apuntes de Gestión de muestras biológicas: Tema-4-Gestion-de-Muestras.pdf
He publicado nuevos apuntes de Gestión de muestras biológicas: Tema-3-Gestion-de-Muestras.pdf
He publicado nuevos apuntes de Gestión de muestras biológicas: Tema-2-Gestion-de-Muestras.pdf
He publicado nuevos apuntes de Gestión de muestras biológicas: Tema-1-Gestion-de-Muestras.pdf
apuntes
-
TRABAJOS GESTIÓN DE MUESTRAS BIOLÓGICAS
He publicado nuevos apuntes de Gestión de muestras biológicas: TRABAJOS GESTIÓN DE MUESTRAS BIOLÓGICAS
apuntes
-
Gestión de muestras biológicas
He publicado nuevos apuntes de Gestión de muestras biológicas: Gestión de muestras biológicas

¡Estás al día!
Has visto todos los archivos